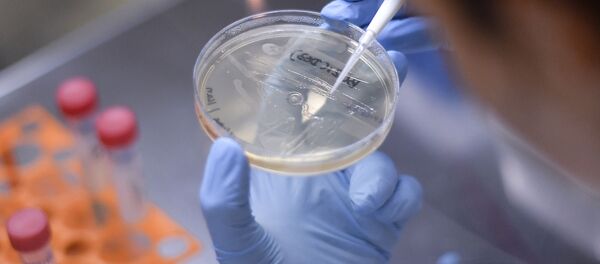

თბილისი, 18 ივლისი — Sputnik. ონკოლოგიური საავადმყოფო თბილისში სარემონტო სამუშაოების გამო რამდენიმე თვით მუშაობას აჩერებს, განუცხადა ჟურნალისტებს ჯანდაცვის მინისტრმა გიორგი წოწკოლაურმა.
რევოლუცია მეცნიერებაში: შექმნილია კიბოს უკურნებელი ფორმების სამკურნალო პრეპარატი >>
მისი თქმით, სარემონტო სამუშაოები უახლოეს დროს დაიწყება და წლის ბოლოს ან გაზაფხულისკენ დასრულდება.
რამდენი დაიხარჯება კლინიკის აღდგენა-მოდერნიზებაზე, ჯერჯერობით დაზუსტებული არ არის. ცნობილია, რომ სარემონტო სამუშაოების შემდეგ კლინიკა 90 პაციენტის ნაცვლად 400-ს მიიღებს.
წოწკოლაურის თქმით, საავადმყოფოს ჰქონდა ფინანსური პრობლემები, ამიტომ ბოლო წლებში მედიკოსებმა ცხრა თვის ხელფასი ვერ მიიღეს. მინისტრის მოადგილემ დაარწმუნა ექიმები, რომ ისინი სრულად მიიღებენ დავალიანებას, ასევე ორთვიან კომპენსაციას. თანხები უახლოესი სამი-ოთხი თვის განმავლობაში ჩაერიცხებათ.
გარდა ამისა, მედიკოსები სამსახურს არ დაკარგავენ- რემონტის დასრულების შემდეგ ისინი საქმიანობას იმავე კლინიკაში გააგრძელებენ - 225-დან 220-მა თანამშრომელმა შესაბამისი მემორანდუმი უკვე გააფორმა.